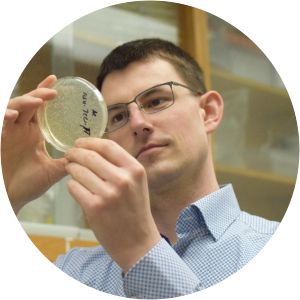
Simon Sretenovic - Researcher

Ngô Bảo Châu
| Use attributes for filter ! | |
| Gender | Female |
|---|---|
| Age | 53 |
| Date of birth | June 28,1972 |
| Zodiac sign | Cancer |
| Born | Hanoi |
| Vietnam | |
| Spouse | Nguyen Bao Thanh |
| Children | Ngô Thanh Hiên |
| Ngô Hiền An | |
| Ngô Thanh Nguyên | |
| Books | Asian-French Summer School on Algebraic Geometry and Number Theory |
| Education | University of Paris-Sud |
| High School for Gifted Students, Hanoi University of Science | |
| HUS High School for Gifted Students | |
| École normale supérieure | |
| Université Paris-Saclay | |
| Awards | Fields Medal |
| Clay Research Award | |
| Oberwolfach Prize | |
| Field | Mathematics |
| Known for | fundamental lemma |
| Parents | Ngô Huy Cẩn |
| Trần Lưu Vân Hiền | |
| Nationality | French |
| Vietnamese | |
| Date of Reg. | |
| Date of Upd. | |
| ID | 1648003 |
Ngô Bảo Châu Life story
Ngô Bảo Châu is a Vietnamese-French mathematician at the University of Chicago, best known for proving the fundamental lemma for automorphic forms. He is the first Vietnamese national to have received the Fields Medal.